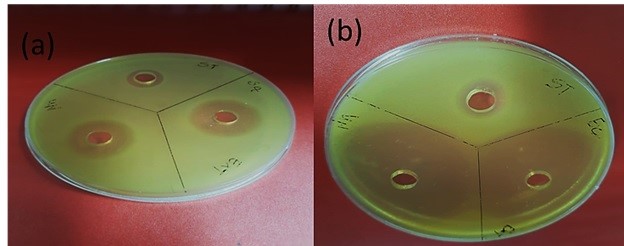
Efectividad antimicrobiana de las nanopartculas de plata contra los microorganismos (a) S. aureus y (b) E. coli

ARTICULO CIENTIFICO
ELABORACIÓN DE NANOPARTÍCULAS DE PLATA SINTETIZADAS A PARTIR DE EXTRACTO DE HOJAS DE ROMERO (Rosmarinus officinalis L.) Y SU USO COMO CONSERVANTE
PREPARATION OF SYNTHESIZED SILVER NANOPARTICLES FROM EXTRACT OF ROSEMARY LEAVES (Rosmarinus officinalis L.) AND ITS USED AS A PERSERVATIVE
ELABORACIÓN DE NANOPARTÍCULAS DE PLATA SINTETIZADAS A PARTIR DE EXTRACTO DE HOJAS DE ROMERO (Rosmarinus officinalis L.) Y SU USO COMO CONSERVANTE
La Granja. Revista de Ciencias de la Vida, vol. 35, núm. 1, pp. 45-58, 2022
Universidad Politécnica Salesiana

Esta obra está bajo una Licencia Creative Commons Atribución-NoComercial-CompartirIgual 4.0 Internacional.
Recepción: 03 Junio 2020
Aprobación: 28 Enero 2021
Publicación: 01 Marzo 2022
Resumen: Las nanopartículas son materiales que pueden llegar a medir entre 1 a 100 nm de longitud, y en la actualidad la propiedad antimicrobiana de las nanopartículas de plata es aprovechada por las industrias para la fabricación de productos de belleza y medicamentos. Las nanopartículas pueden ser sintetizadas a partir de plantas, algas o microorganismos, y también pueden ser obtenidas como productos de combustión. En este estudio se utilizaron extractos de las hojas de romero (Rosmarinus officinalis L.) para la síntesis de nanopartículas de plata (NPs-Ag) con la finalidad de producir un compuesto antimicrobiano para usarse como conservante de frutas. Las NPs-Ag se caracterizaron cualitativa y cuantitativamente mediante análisis fitoquímicos y espectroscopia UV-VIS, presentando una absorción en el rango de 389-418 nm, que corresponde a la resonancia de su plasmón superficial. Además, se empleó la microscopía electrónica de barrido para determinar el tamaño y morfología de las NPs-Ag, observándose una forma esférica de 10 nm de diámetro. Se emplearon dos cepas bacterianas en los ensayos antimicrobianos realizados, la gramnegativa (Escherichia coli) y la grampositiva (Staphylococcus aureus) para comprobar la actividad antimicrobiana de las NPs-Ag. Para E. coli se obtuvo una mejor actividad antibacteriana con un halo de inhibición de 3,21 mm. Posteriormente se usaron las NPs-Ag en manzanas para determinar su uso como conservante, usando la cera de abeja como control untada en la superficie de las frutas, observándose que las nanopartículas sintetizadas alargaron el tiempo de maduración de las frutas.
Palabras clave: Espectroscopia, extracto acuoso, nanopartícula de plata, romero.
Abstract: Nanoparticles are materials that measure from 1 to 100 nm of length. Currently, the antimicrobial property of silver nanoparticles is used by industries for the manufacture of beauty products and medicines. Nanoparticles can be synthesized from plants, algae or microorganisms, and they can also be obtained from combustion products. In this study, extracts of rosemary leaves (Rosmarinus officinalis L.) were used for the synthesis of silver nanoparticles (NPs-Ag) in order to produce an antimicrobial compound to be used as a fruit preservative. NPs-Ag were characterized qualitatively and quantitatively by phytochemical analysis and UV-VIS spectroscopy, showing an absorption in the range of 389-418 nm, which corresponds to their surface plasmon resonance. Furthermore, Scanning Electronic Microscopy was used to determine the size and morphology of the NPs-Ag, observing a spherical shape of 10 nm of diameter. Two bacterial strains were used in the antimicrobial tests, the Gram-negative (Escherichia coli) and the Gram-positive (Staphylococcus aureus) to verify the antimicrobial activity of the NPs-Ag. For E. coli, a better antibacterial activity was obtained with an inhibition halo of 3.21 mm. Subsequently, the NPs-Ag were used in apples to determine their use as a preservative, using beeswax smeared on the surface of the fruit as control, observing that synthesized NPs-Ag prolonged the maturation time of the fruits.
Keywords: Aqueous extract, silver nanoparticle, spectroscopy, rosemary.
Forma sugerida de citar:
Pardo, L., Arias, J., y Molleda, P. (2022). Elaboración de nanopartículas de plata sintetizadas a partir de extracto de hojas de romero (Rosmarinus officinalis L.) y su uso como conservante. La Granja: Revista de Ciencias de la Vida. Vol. 35(1):45-58. http://doi.org/10.17163/lgr.n35.2022.04.
1 Introducción
Las nanopartículas son consideradas materiales donde al menos una de sus longitudes puede llegar a medir entre 1 a 100 nm (Vázquez y Blandón, 2014). En la actualidad las propiedades antimicrobianas de las NPs-Ag y otros metales nobles como el oro (Au), el platino (Pt) y el paladio (Pd) son aprovechados por las industrias para la fabricación de productos de belleza como jabón, champú, detergente, dentífricos, medicamentos, entre otras aplicaciones dentro de la medicina, electrónica, polímeros y cerámicos (Anandalakshmi y Venugobal, 2017; Vera, Farías y Castañeda, 2017). Se han realizado muchas investigaciones sobre el uso de la nanotecnología en la industria alimentaria y el uso y aplicación de las nanopartículas se ha investigado en el área de seguridad alimentaria y calidad, envasado y desarrollo de nuevos alimentos. También las nanopartículas se han utilizado para prevenir la contaminación microbiana en alimentos envasados, mejorar las propiedades físicas de los alimentos y aumentar la biodisponibilidad de sus componentes (Pardo de Santayana, 2018; Thiruvengadam, Rajakumar y Chung, 2018; Ávalos, Haza y Morales, 2013).
Debido a que en la actualidad no existe ninguna legislación que regule la nanotecnología y los nanomateriales en los alimentos, éstos están incluidos en la regulación europea de sustancias químicas (REACH). La autoridad europea de seguridad alimentaria en su publicación sobre la orientación para evaluar los riesgos que representan el uso de la nanotecnología y la nanociencia en los alimentos recomienda la necesidad de desarrollar, validar metodologías y mejorar los estudios sobre la toxicidad y genotoxicidad de las nanopartículas (Ávalos, Haza y Morales, 2013).
Existen diversos tipos de síntesis de nanopartículas metálicas tales como la síntesis mediante método químico usando la reacción redox (agente reductor), método electroquímico, reducción fotoquímica e irradiación ultravioleta, y en todos estos se usan reactivos químicos, se consume energía y se produce contaminación ambiental debido a que se genera una gran cantidad de residuos químicos que tienen como destino final el agua, el suelo o el aire (Vera, Farías y Castañeda, 2017; Chandran y col., 2006; Rodríguez y col., 2013; Torres, 2017).
En la actualidad se están sintetizando nanopartículas mediante la síntesis verde o fisicoquímica verde, la cual produce menor cantidad de residuos contaminantes en comparación con los métodos tradicionales. A través de esta síntesis se obtienen nanopartículas mediante fuentes naturales cambiando los compuestos químicos por extractos naturales de plantas, algas o microorganismos, siendo este método eficaz, fácil, no tóxico, convirtiéndose en una técnica de síntesis de nanopartículas ecológico y eco-amigable (Flores, 2014). Esta técnica no convencional brinda la posibilidad de obtener nanopartículas de metales nobles en soluciones acuosas a temperaturas bajas usando extractos de plantas que actúan como agente reductor, el cual se encuentra en concentraciones elevadas además de contener estabilizadores naturales (Belmares y col., 2015). Por esta razón, para obtener nanopartículas a partir de la síntesis verde se utiliza mayoritariamente las plantas respecto a otras fuentes naturales tales como algas, bacterias, levaduras, entre otros, debido a que éstas son menos tóxicas (Vera, Farías y Castañeda, 2017).
Se han sintetizados nanopartículas de plata a partir de las cáscaras de algunas frutas o vegetales como el banano, el ajo, la sábila, la albahaca, el mático, el cilantro y el romero, los cuales poseen componentes bioactivos con contenido antimicrobiano de forma natural, que de acuerdo a sus propiedades son capaces de producir una reducción en la plata (Madrid, 2017).
El romero (Rosmarinus officinalis L.) pertenece a la familia Lamiaceae, es originario de la región mediterránea de Europa y conocido como una planta aromática y de uso medicinal. Esta planta presenta metabolitos secundarios y aceites esenciales tales como flavonoides, terpenos, ácidos fenólicos, entre otros, y también es usado como condimento y aromatizante (Purca, 2013). El romero hoy en día es aprovechado en la industria alimenticia, farmacéutica, cosmética entre otras. Según Briones (2017), los subproductos más importantes del romero son su extracto acuoso y los aceites esenciales. Además, Avila-Sosa y col. (2011) expresaron que los extractos de plantas extraídos de las hojas del romero poseen compuestos y propiedades antioxidantes y antimicrobianas que fueron utilizadas en la antigüedad como medicina ancestral. La finalidad de este estudio fue extraer y sintetizar nanopartículas de plata a partir del extracto de las hojas de romero y evaluar su actividad antimicrobiana en una fruta tradicional para su conservación.
2 Materiales y Métodos
2.1 Obtención del extracto natural de la hoja de romero
Para la obtención del extracto natural de la planta de romero que favorece el proceso de reducción del nitrato de plata y la formación de las nanopartículas se siguieron los siguientes pasos: primero se realizó la recolección de la planta de romero, posteriormente se procedió a seleccionar las hojas que presentaron mejor estado. Estas se lavaron y desinfectaron con una solución de dióxido de cloro líquido a 10 ppm durante 10 minutos siguiendo la metodología de Garmendia y Vero (2006). Luego se procedió a realizar la reducción del tamaño de las hojas utilizando un mortero, siguiendo la metodología de Martinez, Zuñiga y Sanchez (2013). Posteriormente el extracto obtenido se llevó a punto de ebullición (100 ◦C), hirviendo 100 gr de hojas con 100 ml de agua durante 20 a 25 minutos con agitación constante.
Luego, la muestra se filtró en papel (Whatman, 0,45 µm), y al caldo obtenido se le agregaron 100gr de hojas adicionales para concentrarlo hasta un volumen de 50 ml, repitiendo el procedimiento de extracción anteriormente mencionado. Por último, se filtró el extracto final, se dejó enfriar a temperatura ambiente y luego se almacenó en un recipiente de vidrio. Para conservar el extracto, este se mantuvo en refrigeración a una temperatura de 4 ◦C durante 6 días.
Posteriormente se determinaron los metabolitos secundarios mediante análisis cualitativos y cuantitativos, utilizando tres tipos de extracto cada uno con diferentes solventes; en agua destilada (EA), en etanol (EE) y en agua acidulada (EAC), con la finalidad de utilizar el extracto que presentó mejores resultados por sus compuestos y propiedades químicas para su uso como nanopartícula. A cada uno de estos extractos se le realizaron análisis fitoquímicos para comprobar si este contenía grupos funcionales con propiedades químicas reductoras.
Lo expuesto anteriormente se determinó mediante tamizaje fitoquímico, empleando una extracción sucesiva con solventes de polaridad creciente, iniciando el análisis en el extracto etéreo, seguido del extracto alcohólico y finalmente el extracto acuoso. Esta técnica permitió la identificación de los metabolitos secundarios, mediante la utilización de reactivos apropiados (Tabla 1) que dieron lugar a reacciones coloreadas o precipitación de los mismos (Amaguaña, 2018; Santorum, 2017).
2.2 Síntesis de nanopartículas de plata
Se utilizó el Nitrato de Plata (Número CAS: 776188-8) con una pureza del (95%) como precursor metálico. Para la preparación del nitrato de plata acuoso (AgNO3) se disolvieron 0,034 gramos de AgNO3 (1 mM) en 200 ml de agua destilada, de esta forma se preparó la solución madre. Posteriormente y para comprobar cuál era la concentración adecuada se utilizó el extracto de hojas de romero en volúmenes de 5 ml, 10 ml, 20 ml, 30 ml, 40 ml y 50 ml, siempre manteniendo constantes la solución del nitrato de plata (5 ml). El pH de cada una de las soluciones preparadas se ajustó con hidróxido de sodio (NaOH) al 0,1 N hasta obtener un pH básico entre 8 y 10, medido con un pHmetro (Thermo Scientific ™Orion Star ™A211). La temperatura en la cual se mantuvieron estas soluciones fue de 65 ◦C en agitación constante.
Esta solución se almacenó a 4 ◦C durante 6 días. Posteriormente las NPs-Ag se caracterizaron mediante Espectroscopia UV-VIS en un rango espectral de absorción entre 350-800 nm que corresponde a la resonancia del plasmón superficial de las nanopartículas metálicas, usando un espectrofotómetro (Genesys 10 UV scanning). Para determinar el tamaño y forma de la NPs-Ag obtenida, éstas se observaron con un microscopio electrónico de barrido (Olympus FV3000, Germany) (Sánchez, 2017).

Tabla 1.
Análisis fitoquímico del extracto acuoso, etanólico y acidulado de las hojas de Rosmarinus officinalis L. reactivos usados y resultados esperados
2.3 Efectividad antimicrobiana de las nanopartículas de plata sintetizada
La efectividad antimicrobiana de las NPs-Ag se midió utilizando discos antibiograma frente a la bacteria gramnegativa E. coli y frente a la bacteria grampositiva S. aureus. Para esto, se consideró el tamaño del halo de inhibición (mm) correspondiente al área donde se evidenció la efectividad antimicrobiana (Bauer y col., 1966). En las placas de Petri con medio de cultivo Mueller-Hinton se sembró una concentración celular de 1,5 × 108 UFC/ml de las bacterias grampositiva y gramnegativa usadas. Las placas de Petri, antes de ser inoculadas, se dividieron en tres cuadrantes donde se colocaron el extracto puro, la solución de nitrato de plata y las nanopartículas sintetizadas en cada uno de ellos. Luego, se colocaron los discos antibiogramas y las placas se incubaron a 37 ◦C por 24 horas. Finalmente, se midieron los halos de inhibición bacteriana con la ayuda de un vernier.
2.4 Uso de las nanopartículas de plata sintetizada en una fruta
Para determinar si el extracto de las NPs-Ag sintetizadas puede ser usado como conservante se cubrió la superficie de una fruta de temporada (manzana roja) y se compararon los resultados con la cera de abeja. Se emplearon 12 manzanas rojas (Red delicious) adquiridas en el mercado, las cuales se lavaron y desinfectaron con agua que contenía 10 ppm de cloro por 5 minutos. Posteriormente, se colocaron dos manzanas en cajas conservadoras que estaban divididas en dos celdas. A las manzanas de la caja conservadora 1 no se les agregó nada (blanco), a las dos manzanas de la caja conservadora 2 se les agregó la solución de nanopartículas con la proporción 5:5, a las dos manzanas de la caja conservadora 3 se les agregó la solución de nanopartículas con la proporción 5:10, a las dos manzanas de la caja conservadora 4 se les agregó cera de abejas, a las dos manzanas ubicadas en la caja conservadora 5 se les agregó cera de abeja más la solución de nanopartículas con la proporción 5:5 y a las manzanas colocadas en la caja conservadora 6 se les agregó cera de abeja y la solución de nanopartículas con la proporción 5:10 (Figura 1). Este estudio se realizó durante 30 días, tiempo durante el cual se monitoreó el peso, el color y el grado de madurez de la fruta.

Figura 1.
Representación gráfica del ensayo de las NPs-Ag usadas como conservante (NPs-Ag = Nanoparticulas de plata, M1 =manzana 1 y M2 = manzana2)
3 Resultados y Discusión
3.1 Caracterización fitoquímica del extracto de hoja de romero
Los resultados obtenidos de los análisis fitoquímicos realizados a los extractos acuosos, acidulados y etanólicos se observan en la Tabla 2. La caracterización fitoquímica realizada evidenció la presencia de los metabolitos contenidos en la composición química de esta planta, identificándose 2844,0 mg/kg de terpenos y 24% de fenoles. La presencia de saponinas no se evidenció debido a que no hubo formación de espuma en la muestra, tampoco se observaron resinas por parte del extracto acuoso, pero si compuestos fenólicos y terpenoides, además de azúcares reductores, flavonoides y alcaloides, los cuales son considerados los compuestos químicos de la planta de romero con propiedades reductoras.
Este análisis se realizó para corroborar que el romero es una planta rica en principios activos, los cuales han sido ampliamente estudiados. Dichos compuestos químicos poseen acción en casi todos los órganos del cuerpo humano al poseer altos porcentajes de aceites esenciales cuyos ingredientes activos son flavonoides, ácidos fenólicos, ácido triterpénicos y alcoholes triterpénicos. Las hojas de romero poseen un alto contenido de ácidos rosmarínico y su derivado rosmarisina también está presente en el ácido carnosico que se caracteriza por ser inestable (Avila-Sosa y col., 2011). Como indica Salguero y Pilaquinga (2017) cuando se sintetizan las nanopartículas de plata mediante el uso de extractos de plantas se aprovecha el poder de las propiedades fitoquímicas y etnofarmacológicas de las plantas. En este caso, el romero posee numerosas propiedades beneficiosas, unido a la propiedad bactericida de las nanopartículas de plata, lo cual contribuye a aumentar su utilidad en el área biomédica y microbiológica, sin generar contaminación ambiental. Lo anteriormente acotado puede contribuir a que las NPs-Ag sintetizadas de hoja de romero puedan ser útiles para la conservación de frutas.

Tabla 2.
Análisis fitoquímico del extracto acuoso, etanólico y acidulado de las hojas de Rosmarinus officinalis L.
3.2 Síntesis de las nanopartículas de plata
El extracto de hoja de romero se mezcló con el nitrato de plata (AgNO3) para la formación de las nanopartículas metálica por rutas verdes, resultando una solución de color marrón oscuro y olor picante e intenso a un pH 6 y a una temperatura de 65◦C, como se observa en la Figura 2. De todas las concentraciones preparadas (5:5, 5:10, 5:20, 5:30 y 5:40), la mejor concentración de NPs-Ag se obtuvo al día 3, que fue cuando las soluciones se tornaron de color amarillo a marrón oscuro. Estas soluciones preparadas de NPs-Ag se caracterizaron mediante espectroscopia UV-VIS y las que se encontraron dentro del rango manométrico fueron las que presentaron las proporciones de 5:5, 5:10 y 5:20, como se observa en la Tabla 3. Las proporciones de 5:5 y de 5:10 presentaron el mejor comportamiento debido a que la solución de nanoplata mostró mayor estabilidad en menos tiempo, y porque sus longitudes de ondas se encontraron entre los rangos de 412-418 nm. La proporción 5:5 presentó una longitud de onda de 418 nm al día 1 y de 405 nm al día 5, mientras que la proporción 5:10 la longitud de onda fue de 409 el día 1 y de 412 el día 5.
Los resultados obtenidos coinciden con los reportados por Vera, Farías y Castañeda (2017), quienes, en su trabajo de investigación sobre la síntesis de nanopartículas metálicas por rutas verdes, usaron la técnica del extracto acuoso del romero y el agente oxonitrato de plata (AgNO) para la formación de NPs-Ag, estimando un tiempo de reacción de 30 minutos, dando como resultado un color amarillo lo cual confirma la formación de las nanopartículas y su aplicación como agente antimicrobiano eficaz.
De igual forma, Salguero y Pilaquinga (2017) sintetizaron y caracterizaron nanopartículas de plata preparadas con extracto acuoso de cilantro recubierto con sangre de Drago, observando cambio de color de amarillo a anaranjado cuando se mezcló 10 ml de solución de AgNO3 (10 nM) a 60 ◦C con 2,2 ml del extracto de cilantro.
Del mismo modo, Cardeño y Londoño (2014), usaron el extracto de ajo (Allium sativum) como agente reductor, el cual fue hervido y posteriormente le agregaron una solución acuosa de AgNO3 a una temperatura de 50 a 60 ◦C, método con el cual se observó la reducción de los iones de plata en 30 minutos mediante el cambio de color de la solución de dorado a amarillo. Usando el método de resonancia de plasmón de superficie, para evidenciar la presencia de las NPs-Ag los autores realizaron mediciones UV-visible, encontrando los mejores picos en las soluciones preparadas entre las bandas de 400 y 470 nm, siendo estas longitudes de ondas parecidas a las reportadas en el presente estudio.

Figura 2.
Formación del color marrón oscuro de las NPs-Ag
Al igual que en el estudio realizado por Amaguaña (2018) quien sintetizó nanopartículas de plata a partir de las hojas de sensitiva (Mimosa albida), se evidenció la presencia de las nanopartículas de plata cuando la coloración de la solución se tornó de amarillo verdoso a marrón al agregarle la solución de nitrato de plata, mencionando que esta coloración marrón se observa debido a la resonancia de los plasmones superficiales, lo cual se caracteriza por la formación de las nanopartículas.
Como indican Bijanzadeh, Vakili y Khordad (2012) en su estudio sobre la síntesis de nanopartículas de plata usando métodos químicos y caracterizándolo mediante espectroscopia UV-VIS, observaron la superficie del plasmón para las bandas de absorción de las NPs-Ag a longitudes de ondas entre 395 y 425 nm. Santorum (2017), en su estudio sobre la síntesis de NPs-Ag a partir del matico (Piper adumcun) mencionó que la presencia de las NPs-Ag se observa durante los picos de absorción máximos a 400 nm, y además acotó que el tamaño y la forma de las nanopartículas provocaron que la banda de absorción se desplace a longitudes de ondas mayores. Todos estos resultados coinciden con los reportados en este estudio, donde se obtuvieron valores de resonancia del plasmón entre 405 y 418 para las proporciones de NPs-Ag sintetizadas con una proporción 5:5 y 5:10 (Tabla 3).

Tabla 3.
Caracterización de las mejores proporciones de NPs-Ag por espectroscopia UV-VIS
En la Figura 3 se puede observar que las nanopartículas de plata en el día 1 (pH 10) presentaron un pico de absorbancia máxima a una longitud de ondas de 418 nm con una proporción de 5:5. El día 1 (pH 10) se observó un pico de absorbancia máxima de longitud de ondas mayor a 409 nm con una proporción 5:10. El día 3, las nanopartículas presentaron un pico de absorbancia máxima de longitud de ondas mayor a 405 nm con una proporción de 5:5 (pH 10) y se presentó un pico de absorbancia máxima de longitud de ondas mayor a 412 nm con la proporción 5:10 (pH 10). Todos los picos de absorbancia obtenidos son característicos de las NPs-Ag.

Figura 3.
Representación gráfica del análisis espectrofotométrico durante los días 1 y 3 de las proporciones 5-5 y 5-10
Las nanopartículas de plata de las proporciones 5:5 y 5:10 a los 3 y 5 días (Figura 4) se observaron en el microscopio electrónico de barrido como puntos blancos brillantes y redondeados, detectándose las NPs-Ag en mayor cantidad luego de 3 días con un tamaño de 10 nm en la proporción 5:5 y en menor cantidad luego de 5 días con un tamaño de 10 nm en la proporción 5:10. Como expresa Ávalos, Haza y Morales (2013) la forma de las NPs-Ag influye en la actividad antimicrobiana. Además, se ha comprobado que las formas de triangulo truncado son más efectivas que las formas esféricas y alargadas, las cuales por tener más caras tienden a ser más activas contra los microorganismos.
3.3 Efectividad antimicrobiana de las NPsAg sintetizadas
Se analizó la actividad antimicrobiana de las nanopartículas de plata contra las bacterias E.coli y S.aureus. Como se indica en la metodología, las placas de Petri antes de ser inoculadas con las bacterias mencionadas anteriormente se dividieron en tres cuadrantes: a uno de los cuadrantes se le colocó el extracto puro, a otro la solución de nitrato de plata, y al otro las nanopartículas sintetizadas. Los resultados obtenidos para la bacteria E. coli fueron un halo con un diámetro de 2,88 mm para el extracto, para el cuadrante cuyo contenido era AgNO3 un halo de 1,55 mm de diámetro y para las NPs-Ag el diámetro de halo fue de 3,21 mm. Para la bacteria S. aureus se obtuvo un halo de 2,12 mm; 1,30 mm y 2,18 mm para el extracto, solución de AgNO3 y NPs-Ag, respectivamente. La bacteria E. coli presentó halos con diámetros mayores en comparación con la bacteria S aureus (Figura 5), observándose una mayor eficacia antibacteriana frente a este microorganismo.

Figura 4.
Observación de las nanopartículas de plata a través del microscopio electrónico de barrido proporciones de 5:5 (3 días(a)), (5 días (b)) y 5:10 (3 días (c)) y (5 días (d))
Monge (2009), expresa que estudios realizados para analizar la actividad antimicrobiana de las nanopartículas de plata sintetizadas frente a los microorganismos Escherichia coli y Staphylococcus aureus han reportado que las nanopartículas inhiben más eficientemente a la bacteria E. coli. El microorganismo E. coli es una bacteria gramnegativa que cuenta con una capa en la pared celular conformada por fosfolípidos y lipopolisacáridos, una membrana citoplasmática y una fina capa de peptidoglicano, a diferencia de las bacterias grampositivas como el S. aureus que posee una gruesa capa de peptidoglicano y membrana plasmática lo cual impide que las nanopartículas sintetizadas ingresen con facilidad al interior de la membrana (Villamizar y Monroy, 2015; Cruz-Monterrosa y col., 2017). Además, Fernández (2017) también menciona que la actividad antibacteriana de las NPs-Ag se asocia con la diferencia estructural en la pared celular de ambas bacterias. Lo anteriormente mencionado explica la razón por la cual la inhibición bacteriana fue más eficiente frente a E. coli en comparación a S. aureus.
También es importante acotar que los compuestos bioactivos del extracto de la hoja de romero afectan la membrana celular de las bacterias, y la actividad citotóxica afecta directamente la fase mitótica de las bacterias grampositivas y gramnegativas. Los microorganismos tales como E. coli, Listeria monocitogenes, Salmonella spp. y S. aureus son susceptibles a los componentes del extracto de romero donde prevalecen compuestos como el ácido cafeico, ácido rosmarínico, carnosol, ácido carnosólico y flavonoides (Avila-Sosa y col., 2011; Centeno y col., 2010).
Otros estudios establecen que la plata es oligodinámica ya que posee la capacidad de producir un efecto bactericida a concentraciones bajas, pues es reactivo a sustancias como proteínas, enzimas, ADN, ARN, entre otros (Monge, 2009; Nair y Laurencin, 2007). Además, Fernández (2017) indica que la actividad antimicrobiana de las NPs-Ag se debe a la acción de los iones de plata que actúan interfiriendo en la respiración celular, y una vez en el interior de la célula alteran su sistema enzimático inhibiendo su metabolismo, provocando que el microorganismo pierda toda capacidad de crecer y reproducirse, causando su muerte. Según Anandalakshmi y Venugobal (2017), la acción bactericida de las nanopartículas de plata contra las bacterias gramnegativas ocurre cuando éstas poseen un tamaño entre 1 y 10 nm. En el presente estudio, como se ha mencionado anteriormente, las NPs-Ag mejor sintetizadas presentaron un tamaño de 10nm.
Figura 5.
Efectividad antimicrobiana de las nanopartículas de plata contra los microorganismos (a) S. aureus y (b) E. coli
3.4 Aplicación de las nanopartículas de plata en manzana
El ensayo realizado para comprobar la efectividad de las NPs-Ag sintetizadas, usadas como conservante en las manzanas rojas con la cera de abeja, siendo esta normalmente utilizada como conservante pues inhibe el crecimiento microbiano en las frutas, evidenció un resultado positivo. Esto debido a que las NPs-Ag al igual que la cera de abeja retrasaron el proceso de maduración de la fruta, conservando su color y peso inicial desde el día 1 hasta el día 30. Como se observa en la Figura 6, las manzanas que no contenían ningún conservante cambiaron su color, perdieron peso y mostraron descomposición después de 30 días de ensayo. Algunos estudios demuestran que las nanopartículas podrían ser aplicadas para proteger alimentos incorporándolas en sus empaques, aunque esta posibilidad todavía está siendo investigada por no existir ninguna legislación sobre la aplicación de NPs-Ag en alimentos. Las nanopartículas podrían aplicarse a un recubrimiento para los frutos o podrían emplearse para la fabricación de materiales de envase activos que protejan a alimentos contra los patógenos (Ávalos, Haza y Morales, 2013; Aguilar, 2009).

Figura 6.
Cajas conservadoras con las manzanas al inició del ensayo y B. Caja conservadora a los 30 días (1 control, 2 NPs-Ag 5:5, 3 NPs-Ag 5:10, 4 cera de abeja, 5 cera de abeja y NPs-Ag 5:5 y 6 cera de abeja y NPs-Ag 5:10)
An y col. (2008), evaluaron los efectos al aplicar un recubrimiento con NPs-Ag en espárragos postcosechados. El recubrimiento redujo la pérdida de peso, mantuvo la firmeza, redujo la pérdida de clorofila y la formación de ácido ascórbico, retardó los cambios del color e inhibió el crecimiento microbiano, aumentando la vida postcosecha de los espárragos 10 días más. Aguilar (2009) en su investigación sintetizó NPs-Ag por reducción química para evaluar la actividad antifúngica in vitro e in situ, en contra del hongo Colletrotrichum gloesporioides, hongo causante de la antracnosis de la papaya. Las pruebas in vitro mostraron un efecto fungistático del 90% de inhibición, aunque las papayas recubiertas con la película que contenía las nanopartículas de plata presentaron secciones oscuras sobre la superficie, afectando la apariencia del fruto.
En el estudio realizado por Villamizar y Monroy (2015), las NPs-Ag sintetizadas de Aspergilus flavus se usaron para la conservación de tomates de árbol y uvillas. Las frutas se empacaron en bolsas de polietileno untadas con las NPs-Ag, observándose la disminución del crecimiento de levaduras y bacterias grampositivas y gramnegativas. Además, Li y col. (2009) en su investigación untaron nanopartículas de plata en un empaque que contenía, dióxido de titanio y kaolin para preservar dátiles chinos, demostrando que los materiales que contenían el empaque mantuvieron la calidad de los frutos por más tiempo en comparación con los frutos empacados en el recipiente normalmente empleado.
4 Conclusiones
Se sintetizaron nanopartículas de plata a partir del extracto acuoso de las hojas de romero, y la caracterización cualitativa y cuantitativa de las NPs-Ag obtenidas mediante el análisis fitoquímico demostró la presencia de metabolitos secundarios tales como ácidos fenólicos, flavonoides, terpenoides, y compuestos reductores. El cambio de color de la solución del extracto de hoja de romero de amarillo a marrón oscuro y olor picante e intenso evidenció la formación de las NPs-Ag. La caracterización realizada mediante espectrofotometría UV-VIS demostró que las proporciones 5:5 y 5:10 fueron las mejores debido a que presentaron longitudes de ondas entre 212-418 nm y mayor estabilidad en el tiempo. El análisis mediante microscopía electrónica de barrido evidenció nanopartículas de forma esférica de 10 nm de diámetro. Las NPs-Ag presentaron mayor inhibición bacteriana frente a la bacteria gramnegativa E. coli en comparación con la inhibición bacteriana presentada frente a la grampositiva S. aureus. Por otro lado, las NPs-Ag sintetizadas de la hoja de romero usadas como conservante en las manzanas retardaron el proceso de maduración, mantuvieron el peso inicial, e impidieron la contaminación microbiana y la descomposición de la fruta durante 30 días.
Referencias
Aguilar, M. (2009). «Síntesis y caracterización de nanoparticulas de plata: efectos sobre Colletotrichum gloesporioides». Tesis de Maestría. Instituto Politécnico Nacional. Online: https://bit.ly/ 3eN2QF9.
Amaguaña, P. (2018). «Síntesis y caracterización de nanopartículas de plata usando como reductor químico el extracto acuoso de las hojas de sensitiva (Mimosa albida)». Tesis de Grado. Pontificia Universidad Católica del Ecuador. Online: https: //bit.ly/3awSRCy.
An, J. y col. (2008). «Physical, chemical and microbiological changes in stored green asparagus spears as affected by coating of silver nanoparticles-PVP». En: Lebensmittel Wissenshaft and Technologie 41.6, 1100-1107. Online: https:// bit.ly/3auhXC5.
Anandalakshmi, K. y J. Venugobal (2017). «Green Synthesis and Characterization of Silver Nanoparticles Using Vitex negundo (Karu Nochchi) Leaf Extract and its Antibacterial Activity». En: Medicinal Chemistry 07.07, 218-225. Online: https: //bit.ly/3xddb5u.
Ávalos, A., A. Haza y P. Morales (2013). «Nanopartículas de plata: aplicaciones y riesgos tóxicos para la salud humana y el medio ambiente». En: Revista Complutense de Ciencias Veterinarias 7.2, 1-23. Online: https://bit.ly/3aW88gu.
Avila-Sosa, Raúl y col. (2011). «Romero (Rosmarinus officinalis L.): una revisión de sus usos no culinarios». En: Ciencia y mar 15.43, 23-36. Online: https://bit.ly/3h3MGcW.
Bauer, W. y col. (1966). «Antibiotic susceptibility testing by a standardized single disk method». En: American Journal of Clinical Pathology 45.4, 493-496. Online: https://bit.ly/3veidNr.
Belmares, S. y col. (2015). «Síntesis y caracterización de nanopartículas de oro, plata y fierro por el método de fisicoquímica verde». En: Tercer Foro de Divulgación Científica y Tecnológica. Online: https://bit.ly/338D6NT.
Bijanzadeh, A, M Vakili y R. Khordad (2012). «A study of the surface plasmon absorption band for nanoparticles». En: International Journal of Physical Sciences 7.12, 1943-1948. Online: https: //bit.ly/3dEGqqg.
Briones, A. (2017). «Diseño y funcionalidad en sistemas in vivo denanocápsulas líquidas de aceite de romero (Rosmarinus officinalis L.)» Tesis de grado. Universidad Veracruzana. Online: https: //bit.ly/2RKwFy2.
Cardeño, L. y M. Londoño (2014). «Síntesis verde de nanopartículas de plata mediante el uso de ajo Allium sativus». En: Revista Soluciones de Postgrado 6.12, 129-140. Online: https://bit.ly/33cRFzS.
Centeno, S. y col. (2010). «Antifungal activity of extracts of Rosmarinus officinalis and Thymus vulgaris against Aspergillus flavus and A. ochraceus». En: Pakistan Journal of Biological Sciences 13.9, 452-455. Online: https://bit.ly/3dFe0fH.
Chandran, S. y col. (2006). «Synthesis of Gold Nanotriangles and Silver Nanoparticles Using Aloe vera Plant Extract». En: Biotechnology Progress 22.2, 577-583. Online: https://bit.ly/2QPMIug.
Cruz-Monterrosa, R. y col. (2017). «Nanotecnología en la industria alimentaria. Nanopartículas usadas en la Conservación de la carne». En: Agro Productividad 10.10, 39-46. Online: https://bit. ly/2QnKKkD.
Fernández, B. (2017). «Estudio de las aplicaciones biomédicas de las nanopartículas de plata». Tesis de grado. Universidad de Sevilla. Online: https://bit.ly/3sCKStO.
Flores, C. (2014). «Nanopartículas de plata con potenciales aplicaciones en materiales implantables: síntesis, caracterización fisicoquímica y actividad bactericida». Tesis Doctoral. Universidad Nacional de la Plata. Online: https://bit. ly/2QGvgbV.
Garmendia, G. y S. Vero (2006). «Métodos para la desinfección de frutas y hortalizas». En: Horticultura 197, 18-27. Online: https : / / bit . ly / 3xeBJLs.
Li, H. y col. (2009). «Effect of nano-packing on preservation quality of Chinese jujube (Ziziphus jujuba Mill. var. inermis (Bunge) Rehd)». En: Food Chemistry 114.2, 547-552. Online: https://bit.ly/ 3sHOf2F.
Madrid, A. (2017). «Síntesis y caracterización de nanopartículas de plata a partir de varios extractos pigmentados de dos plantas para su aplicación en celdas solares híbridas». Tesis de grado. ESPE. Online: https://bit.ly/3aZwHcl.
Martinez, M., E. Zuñiga y A. Sanchez (2013). «Método de síntesis de nanopartículas de plata adaptable a laboratorios de docencia relacionado con la nanotecnología». En: Mundo Nano. Revista Interdisciplinaria en Nanociencias y Nanotecnología 6.10. Online: https://bit.ly/3ncvpiY.
Monge, M. (2009). «Nanopartículas de plata: métodos de síntesis en disolución y propiedades bactericidas». En: Anales de la Real Sociedad Española de Química 105.1, 33-41.Online: https://bit.ly/ 3aZgMdZ.
Nair, L. y C. Laurencin (2007). «Silver Nanoparticles: Synthesis and Therapeutic Applications». En: Journal of Biomedical Nanotechnology 3.4, 301-316. Online: https://bit.ly/3sCZd9C.
Pardo de Santayana, M. (2018). «Nanotecnología y Alimentación.» Trabajo fin de Grado. Universidad Complutense de Madrid. Online: https:// bit.ly/2Rn4R2N.
Purca, P. (2013). «Efectividad antibacteriana "in vitro"del extracto de Rosmarinus officinalis (romero) sobre flora salival». Tesis de grado. Universidad Nacional Mayor de San Marcos. Online: https: //bit.ly/3vfogRY.
Rodríguez, M. y col. (2013). «Mechanical and barrier properties of film elaborated with rice and banana flour reinforced with nanoparticles: study with response surface». En: Revista Mexicana de Ingeniería Química 12.1, 165-176. Online: https : //bit.ly/3aUW8f5.
Salguero, S. y F. Pilaquinga (2017). «Síntesis y caracterización de nanopartículas de plata preparadas con extracto acuoso de cilantro (Coriandrum sativum) y recubiertas con látex de sangre de drago (Croton lechleri)». Tesis de Maestría. Pontificia Universidad Católica. Online: https://bit.ly/ 32EIoAx.
Sánchez, M. (2017). «Nanopartículas de plata: Preparación, caracterización y propiedades con aplicación en inocuidad de los alimentos». Tesis de Maestría. Universidad Nacional de Educación a distancia. Online: https : / / bit . ly / 3tWdpMx.
Santorum, N. (2017). «Síntesis y caracterización de nanopartículas de plata empleando el extracto de las hojas de Matico (Piper adumcun) como un agente reductor». Tesis de grado. Pontificia Universidad Catolica del Ecuador. Online: https:// bit.ly/3vcarn1.
Thiruvengadam, M., G. Rajakumar e Ill-M. Chung (2018). «Nanotechnology: current uses and future applications in the food industry». En: 3 Biotech 8.74, 1-13. Online: https://bit.ly/33dyV3y.
Torres, I. (2017). «Síntesis verde y caracterización de nanopartículas de oro y plata mediante el uso de algunas plantas endémicas del Ecuador». Tesis de Grado. Escuela Politécnica Nacional. Online: https://bit.ly/3gyO0Er.
Vázquez, M. y L. Blandón (2014). «Comportamiento antimicrobiano de nanopartículas de plata sintetizadas electroquímicamente». En: Cuaderno Activa 6.1, 99-107. Online: https://bit.ly/3xgdaxN.
Vera, G., L. Farías y A. Castañeda (2017). «Síntesis de Nanopartículas Metálicas por Rutas Verdes». En: Journal of Bioprocess and Chemical Technology. Revista Científica de la Universidad Autónoma de Coahuila 9.19, 15-20. Online: https://bit.ly/2S0ZEhv.
Villamizar, G. y P. Monroy (2015). «Uso de Nanopartículas de plata en el control de microorganismos patógenos presentes en alimentos». En: @limentech, Ciencia y Tecnología Alimentaria 13.1, 54-59. Online: https://bit.ly/3nHIXDs.
Enlace alternativo
https://revistas.ups.edu.ec/index.php/granja/article/view/4101 (html)
